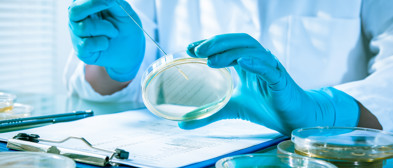
Explore our complete diagnostic range

Explore our complete diagnostic range
For nearly 70 years we have been developing diagnostic tools that help to improve patient outcomes
Explore products by markets
Explore our complete diagnostic range
For nearly 70 years we have been developing diagnostic tools that help to improve patient outcomes
Explore products by markets


Mast Group is a leading manufacturer of high-quality microbiology products, supplying clinical, pharmaceutical, industrial, and research laboratories worldwide. With decades of expertise in microbiological diagnostics and laboratory solutions, microbiology remains at the core of our business.


Mast Group offers a range of Molecular diagnostic tools designed to suit a diverse range of application settings and throughput needs. From high throughput centralised laboratory testing through to point of need, we are able to provide specialised assays and automation that serve a variety of markets.


Gastrointestinal Diseases and disorders affect the digestive system and gastrointestinal tract. Mast Group offers a range of diagnostic products to help treatment


Mast Group has a strong product portfolio for investigation of the immune system through identification and detection of immunological markers using Flow Cytometry, ELISA, ELISPOT and agglutination techniques. Additionally, In vitro diagnostic products to screen donated blood and blood fractions, prior to transfusion, for the bacterial and viral causative agents of infectious disease.


Mast Group provides specialist pharmaceutical services to support the development, evaluation, and commercialisation of novel antimicrobial compounds. Through mastpharma® development and mastpharma® stability services, we partner with pharmaceutical companies to deliver validated diagnostic solutions that support clinical trials and successful market launch.


Urinalysis is one of the fundamental clinical diagnostic laboratory services, providing fast and accurate insights into a patient’s health. As one of the most commonly requested clinical laboratory tests, urinalysis is essential for identifying urinary tract infections (UTI), kidney disease, metabolic disorders, and early indicators of systemic illness. Mast Group’s well-established urinalysis product range has become a trusted solution for supporting the identification and treatment of UTIs.